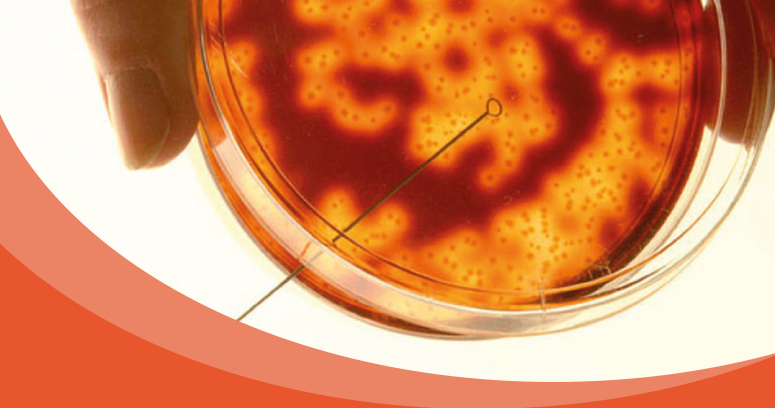
www.meningitisnow.org

Mandarin Duck
Majestic and Highfalutin
Yea I can see why you believed in him now lol
Functional drug addict?
Bro he's probably the amongst the healthiest in politics.
You have alot to learn, they ALL ADDICTS!
Do you know that politicians have a secret clinic that they go to?
Alot of times during presidential debates those candidates on the podium sniffed coke
Look at Obama and Bush during Trump's inauguration, they were high. Even Michelle Obama said I don't wanna go and get high.
All of them either drug addicts or alcoholics